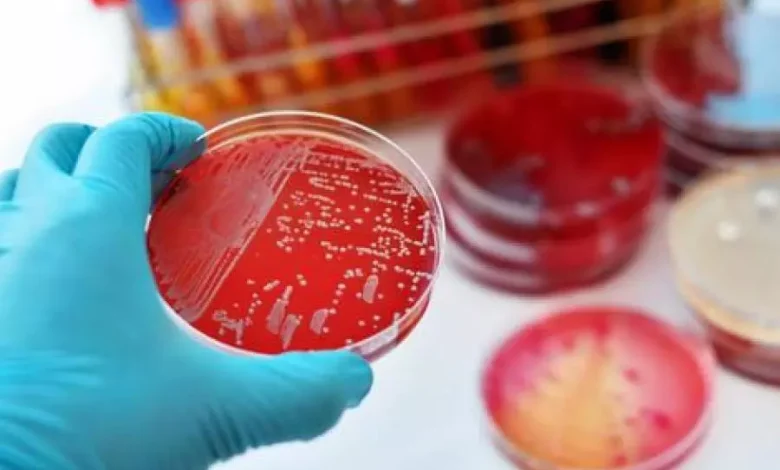

Afrique : plus de 20 400 cas de diphtérie détectés, dont 1 200 décès, depuis le début de l’année
Plus de 20 000 cas suspects de diphtérie ont été détectés depuis le début de l’année en Afrique, dont plus de 1 200 décès, a indiqué l’Organisation mondiale de la santé (OMS), qui a évalué le risque d’une nouvelle propagation de la maladie sur le continent comme élevé.
Du 1er janvier au 2 novembre 2025, en Guinée, au Mali, au Niger, au Nigeria, au Tchad et en Afrique du Sud notamment, «un total de 20 412 cas suspects de diphtérie, dont 1 252 décès, ont été enregistrés», selon le bulletin d’information de l’OMS.
Le taux de létalité moyen était de 6,1%. Ces dernières semaines, la situation «s’est aggravée» au Mali et au Niger, le nombre de malades a augmenté et les flambées se sont étendues géographiquement, selon la même source. La recrudescence de la diphtérie en Afrique est devenue «un problème de santé publique majeur», souligne l’OMS.
«Au niveau régional, le risque pour la santé publique est considéré comme élevé en raison de l’expansion géographique potentielle des flambées, du taux de létalité élevé, des ressources insuffisantes pour y faire face et des faiblesses des systèmes de surveillance et de contrôle en laboratoire», a-t-elle relevé.
La situation humanitaire dans plusieurs pays touchés par la diphtérie, dont le Tchad, le Mali, le Niger et le Nigeria, «augmente la probabilité d’une transmission contenue de l’infection et complique les mesures d’intervention».
Les perturbations causées par la pandémie de Covid-19 ont entraîné «une baisse significative de la couverture vaccinale». Le risque que les flambées de diphtérie en Afrique posent pour la santé au niveau mondial «est considéré comme faible», car la plupart des pays en dehors de la région africaine «ont mis en place des programmes de vaccination et des systèmes de surveillance adéquats».
L’OMS a recommandé de constituer des stocks continentaux d’antitoxine diphtérique, d’antibiotiques et de fournitures de laboratoire dans les centres régionaux de Dakar et Nairobi.
La diphtérie est une maladie bactérienne qui affecte les voies respiratoires supérieures et, plus rarement, la peau. La toxine produite par la bactérie provoque des lésions du muscle cardiaque et du tissu nerveux. Récemment, malgré l’existence d’un vaccin sûr et efficace, les flambées surviennent de plus en plus fréquemment en raison d’une vaccination insuffisante.




